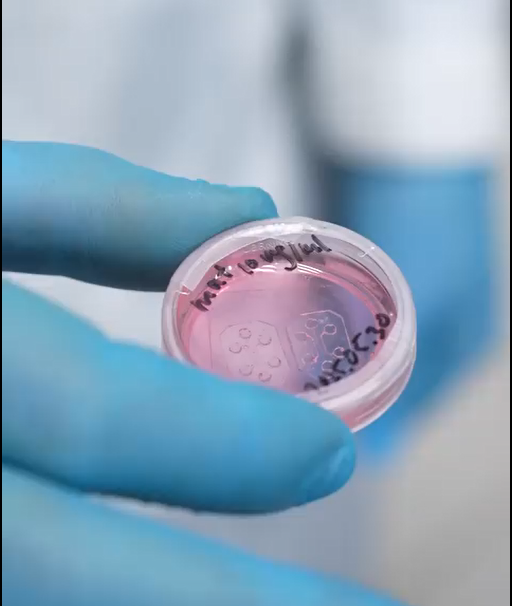

День российской науки, отмечаемый ежегодно 8 февраля, учрежден Указом Президента Российской Федерации № 717 от 7 июня 1999 года. Эта дата была выбрана неслучайно: именно 8 февраля 1724 года император Петр I подписал указ о создании Академии наук и художеств в Петербурге, заложив основы организации систематического изучения естественных наук и искусств в России.
Исторический путь российской науки
Создание Петербургской академии наук стало важнейшим событием в истории отечественной науки. Именно здесь работали многие известные русские и иностранные ученые, сделавшие значительные открытия в математике, физике, химии, биологии и других областях. Академия стала центром подготовки высококвалифицированных кадров и местом распространения знаний среди населения.
Позднее академия преобразовалась в Императорскую академию наук, а позже получила название АН СССР. Сегодня Российскую академию наук возглавляет РАН, объединяя тысячи институтов и лабораторий по всей стране.
Важнейшие события и реформы
За свою долгую историю российская наука пережила ряд реформ и изменений. Наиболее значительным периодом стал XX век, когда советские ученые внесли огромный вклад в освоение космоса, разработку атомной энергетики, медицины и оборонных технологий. Такие имена, как Курчатов, Королев, Ландау, Павлов и Сахаров стали символами научно-технического прорыва советской эпохи.
Современный этап
Современная российская наука продолжает развиваться и адаптироваться к новым условиям глобализации и цифровизации. Упор делается на поддержку фундаментальных исследований, подготовку квалифицированных кадров и интеграцию российского научного сообщества в международное пространство.
Несмотря на трудности, отечественная наука сохраняет высокий уровень квалификации и репутацию в мире благодаря многочисленным прорывам в науке и технике.
Проект ЦНИЛ ИФМ
В этой лаборатории много лет исследуются клеточные технологии. И основное направление связано с исследованием нейронов.
То есть мы выращиваем из нейронов, взятых из эмбрионов животных, нейронные сети, которые функционируют по таким же принципам. Мы берём специальные микроэлектродные матрицы, на дне которых выращиваем нейронные сеть и в течение нескольких месяцев нейроны из эмбрионов формируют синаптические связи и начинают генерировать электрическую активность.
Лаборатория на чипе позволяет с помощью микрофлюидных технологий располагать клетки различного типа в определённой последовательности, в определённой структуре, так же как в органах у нас имеют разные слои и взаимодействуют между собой.
Клетки взаимодействуют и тем самым формируют некую функцию в органе в почках, в лёгких или в мозге. Клетки взаимодействуют с определённой структурой. Такую структуру мы можем моделировать уже в лаборатории, где мы располагаем клетки очень близко друг к другу разного типа и они начинают взаимодействовать так же, как в органах. В таких чипах мы можем уже моделировать различные заболевания, различные клеточные патологии и тестировать различные лекарства, которые фармкомпания ещё только начинает тестировать.
Это удобно, потому что здесь для разработки новых лекарств мы Мы не используем животных или целого человека. А мы делаем модель органа на таком чипе, на такой чашке Петри. И в такой модели органа очень просто или дёшево и удобно тестировать новые лекарства для лечения различных заболеваний.
Алексей Пимашкин, заведующий лабораторией клеточной инженерии Института фундаментальной медицины ПИМУ.